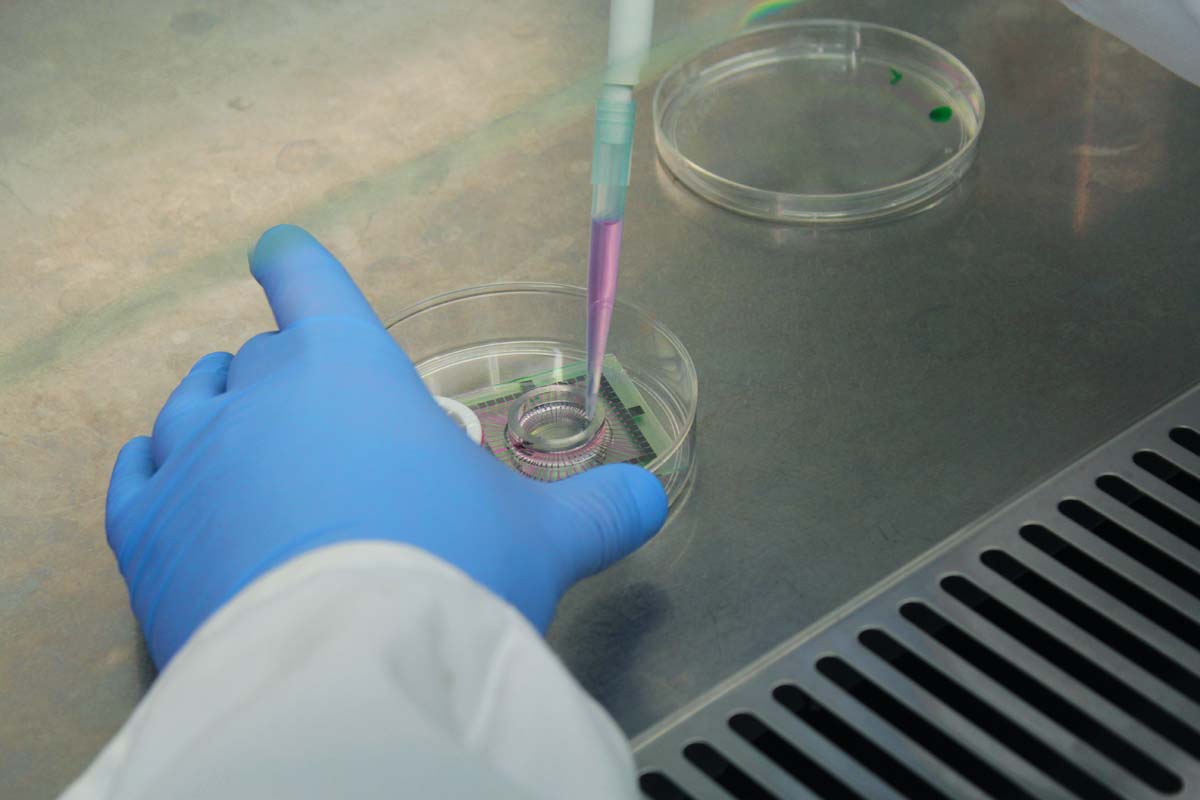

About Snowflake (or Snezinka)
Snowflake explores and critiques the idea of eternal life made possible by cryonics. Cryonics, a field of research focused on the preservation of a body in liquid nitrogen, presents certain hopes for those wishing to be cryogenically preserved in order to be “awoken” in the future. The concept of cryonics was first introduced in 1962 by the founder of the Cryonics Institute, Robert Ettinger. In The Prospect of Immortality and Man into Superman Ettinger places great hope in nano/bio-technologies to restore the tissues and ultimately revive frozen bodies, although it should be noted that science is yet to resolve issues surrounding how to repair vital tissues and in particular maintain the brain plasticity necessary for knowledge, memories and identity. Although, the concept of cryonics (and its social and cultural implications) has been widely explored in many science fiction texts, it appears that our current times attempts to commercialize these yet-to-be-realised technologies via biomedical narratives of hope as well as fear.
Snowflake is a symbolic art object created by Boryana Rossa, Guy Ben-Ary and Oleg Mavromatti that conceptually and materially examines a scenario regarding biotechnologies’ manipulation of brain plasticity in order to create false memories, and the ethical and aesthetical implications of this potential on the border that separates the physical and the psyche. In 2006 Rossa and Ben-Ary worked in the Steve Potter Lab in Georgia Tech (a laboratory for neuro-engineering) where they grew neural networks from mouse neurons, creating a series of living ‘brains’ that could produce and receive data and stimulation through 60 electrodes. By repeatedly stimulating the neural networks with the image of a snowflake, Rossa and Ben-Ary molded the network’s plasticity or bio-engineered the image of a snowflake into the networks’ “memory”. They then cryogenically preserved the snowflake “engraved” neural networks at -80°C. At the time of cryongenic preservation Rossa and Ben-Ary had yet to conceive of a definite outcome for these frozen neural networks that carried a memory of a snowflake. Moreover, once their residency finished they were unable to take them with them as the frozen networks had to remain at -80 C. And so this artwork was left behind, preserved and conserved in a freezer. However, 10 years later the freezer unit housing the frozen neural network broke down and the fragile material thawed and died.
In Neuroplastika Rossa, Ben-Ary and Mavromatti pay homage to the original project from 2004. However this time, rather than using mouse neurons, they display in a liquid nitrogen container, a neural network made from Guy Ben-Ary’s neurons, stimulated with the same image of a snowflake before being frozen at -80 C. Assembled to evoke thoughts about the technological future, as well as where we are placed within the process of its creation, Snowflake asks to what extent has cryonic technology changed the ethical and/or statutory considerations required to cope with external commercial interventions with memory and plasticity?
The Process
Snowflake @ Nervoplastica
Collaborators
(born 1972) is a Bulgarian interdisciplinary artist and curator making performance art, video and photographic work.Her artwork has been exhibited internationally including most notably at the National Gallery of Fine Arts inSofia,Goethe Institute, the Moscow Biennial, the Elizabeth A. Sackler Center for Feminist Art at the Brooklyn Museum,Exit Art, Biennial for Electronic Art in Perth, and Foundation for Art and Creative Technologies in Liverpool. She frequently collaborates with artist and filmmakerOleg Mavromatioften under the title ULTRAFUTURO – an international art collective started in 2004. Some of her awards and grants include the Gaudenz B. Ruf Award for New Bulgarian Art,the Essential Reading for Art Writers Award from the Institute of Contemporary Art in Sofia,and aNew York Foundation for the ArtsFellowship in 2014 in Digital/Electronic Arts. She is an Assistant Professor of Transmedia at Syracuse University
(1965, Russia) is an interdisciplinary artist and filmmaker, a prominent representative of the Moscow Actionism, a phenomenon of the radical performance art scene in 1990s Moscow. He has been a member of legendary Moscow performance art groups such as “Expropriation of the Territory of Art” and NECEZIUDIK. In 1995 Mavromatti establishes the independent film union SUPERNOVA, manifested as a fortress of Moscow radical cinema. Mavromatti has been legally prosecuted for his critical performance art and film work (such as the famous performance “Ne ver’ glazam” (“Do Not believe Your Eyes”), 2000, for what his art and film archive has been confiscated in 2000. Therefore many of his early works are completely lost or accessible only from VHS copies. Mavromatti left the country in 2000 and since then he lives in Bulgaria and New York. In Bulgaria, Rossa and Mavromatti established art collective ULTRAFUTURO – an international group of artists engaged with issues of technology, science and their social implications. They have been included in the Biennial for Electronic Art, Perth (BEAP) and shown at Foundation for Art and Creative Technologies (FACT), Liverpool; Society for Art and Technology (SAT), Montreal etc.